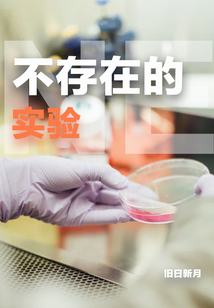
nonexistent experiment

nonexistent experiment
by Author: old sun and new moon
Summary At the beginning of the year, I accidentally read a paper about virtual patients in the journal Science, which caught my attention. If this technology can be realized, it will definitely bring medical care into a new realm.Under this framework, I conceived such a story.A hundred years later, human beings have caused environmental changes due to overconfidence, the polar permafrost has thawed, and a virus that has never been discovered by human beings is rampant.In order to develop vaccines, so that the few humans can continue, humans have developed a new set of experimental methods to develop vaccines...But everything is not smooth sailing, nor should it be taken for granted. The development of science and technology is also accompanied by the expansion of human desires. In the end, where will this non-existent experiment lead to the future of mankind?If you are tired of Shuangwen, tired of upgrading and fighting monsters, let's talk about the thinking brought by scientific development.Looking forward to your attention!——Old Sun and New Moon Novel keywords: Non-existent experiment no pop-up window, non-existent experiment txt complete download, non-existent experiment latest chapter read
Similar Novels
View All
Han Zong: Starting from the Undercover New World
104 chaps
People are in the United States, the traveling frog brings back the emperor's armor
6 chaps

Poison Consort and Her Tyrant
106 chaps

Begins with Zombie Daoist
154 chaps

Comics: Beginning with Giants
106 chaps

Douluo: I am an ice shooter, my ice power is invincible
231 chaps